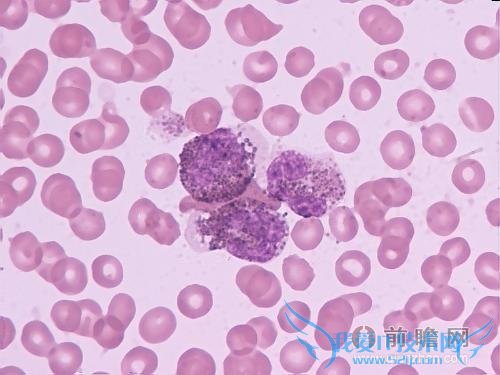
丈夫白血病妻子引产

欢迎您访问我爱IT技术网,今天小编为你分享的是新闻资讯是:【新婚丈夫患白血病妻子引产7月胎儿:爱我就别拖累我】,下面是详细的分享!
新婚丈夫患白血病妻子引产7月胎儿:爱我就别拖累我
虽说“夫妻本是同林鸟,大难临头各自飞”的俗语流传甚广,但夫妻间没了感情尚且还有亲情存在,因而狠心抛弃另一半的人始终是寥寥无几。但是,这为数不多的几率就发生在了连云港的孙先生身上,因为自己在婚后不幸患上白血病,已怀有 7 个月身孕的“妻子”阿平就私自偷偷引产,让孙先生心寒不已。对于这幕现实版的《爱我就别拖累我》,头条我爱IT技术网的邓高远只想说“磨难才是夫妻感情的试金石”。
丈夫患病妻子引产,原来是有实无名的夫妻

孙先生和阿平经人介绍后迅速陷入热恋,并于一年后在家人的操办下举行了婚礼,但双方始终没有前往民政局领取结婚证。让小俩口没有想到的是,仅仅在婚后 3 个月,孙先生就因身体不适被医院确诊为白血病,而此时阿平已怀有 7 个月身孕,正当家人为给孙先生治病忙的焦头烂额时,新婚“妻子”阿平却偷偷来到医院做了引产手术,“妻子”在自己患病时亲手扼杀掉两人的爱情结晶,这让孙先生感到难以忍受。
白血病并非是不治之症,通过化疗和骨髓移植都可以进行有效治疗,然而阿平在丈夫患病后非但没有尽到家人的义务,反而第一时间做出打胎举动,真是让人感到十分心寒。纵然两人没有领取那一纸婚书,但感情和婚礼都是不争的事实,因为对方患病就抛夫弃子,难道忘了“不论生老病死都不离不弃”的承诺吗?所谓“买卖不成仁义在”,就算下定决心要堕胎走人,也要提前和男方家人沟通商量,毕竟肚子里怀的是条小生命,而不是浮萍草芥。
虽说新婚“妻子”的做法在外人看来过于冷血,但从法理和常理的角度来看也是情有可原,孙先生和阿平自始至终都没有领取结婚证,这也就意味着两人只是非法同居,因而阿平的私自堕胎行为并未侵害孙先生的生育权。此外,白血病还有一定遗传易感性,有白血病家族史的人患有白血病的几率比正常人要高,只能说,女方将孩子生下来是有情有义,若是不愿被男方拖累也是人之常情。
家家有本难念的经,网络键盘侠太可怕
连云港孙先生的新闻一出,邓高远就本能的就联想到了此前“25 岁小伙患白血病,女友在病房向他求婚”的事例,同样是另一半身患白血病,同样是有一段刻骨铭心的感情,一个选择陪伴在病床旁不离不弃,另一个选择打退堂鼓跪求别拖累,孰是孰非似乎一目了然。但在邓高远看来,对人性的判断远远不能通过黑白选择来衡量,毕竟“家家有本难念的经”,不换位思考根本无法理解当事人的痛苦和无奈,只能说 25 岁的乐山小伙是幸运的,因为他得到了人世间最为珍稀的情感。

对于孙先生的遭遇,许多网络键盘侠都表达了自己的同情,并对阿平的做法予以激烈抨击,但邓高远却认为,“靠敲键盘来占据道德制高点”的行为更不值得提倡。正所谓“己所不欲,勿施于人”,试问坐在电脑屏幕前声讨他人的键盘侠,又有几个能真正做到不抛弃,不放弃?如果连自己都没办法做到出淤泥而不染,那只能是空有一颗“圣母心”罢了,实在没有资格对他人评头论足。
邓高远无意要求阿平做出改变,也无意让网络键盘侠停止非议,只求无愧于心就好。
关于新婚丈夫患白血病妻子引产7月胎儿:爱我就别拖累我的用户互动如下:
相关问题:我是胎儿7个月停育,7月2号正常引产,昨天去做了染...
答:七个月妊娠胎死宫内,一般费用和生孩子差不多的,需要大约1千5百元左右吧, >>详细
相关问题:
答: >>详细
相关问题:
答: >>详细
- 评论列表(网友评论仅供网友表达个人看法,并不表明本站同意其观点或证实其描述)
-
